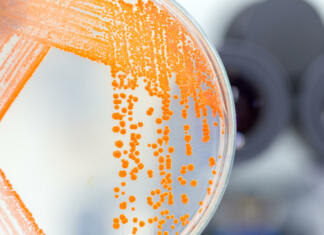
Serratie, rožnata sluz v kopalnici: Kako se je znebiti? Serratia marcescens je vzrok za nastanek rožnate sluzi v kopalnici

Nadja Jurca
To se zdaj dogaja s cenami nepremičnin v Sloveniji
V drugem četrtletju letošnjega leta so cene stanovanj v Ljubljani v povprečju padle za 100 evrov na kvadratni meter, ugotavljajo pri Arvio, slovenskem podjetju,...
Kako odstraniti neprijeten vonj oblačil?
Ko se neprijetne vonjave zažrejo v tkanino, jih je skorajda nemogoče odpraviti. Oblačilo takoj po pranju sicer prijetno diši, a se kmalu po tem,...
Zimske pnevmatike: cene letos močno navzgor
V Sloveniji zakonodaja obvezno ustrezno zimsko opremo za vozila zapoveduje med 15. novembrom in 15. marcem. Kot poroča Žurnal24.si, bo treba letos za zimske...
Ogrevanje v prehodnem obdobju
Noči in jutra se ohlajajo, dnevne temperature so še dovolj visoke. Kaj pa ravno toliko stisne hlad, da polno ogrevanje ni smiselno, brez pa...
Skrb za trato jeseni
Ob koncu poletja, ko je dolgo sušno obdobje načeloma že za nami, se skrb za trato ne konča. Da bi travne bilke preživele bližajoče...
Prosojni paneli namesto oken? Zakaj pa ne.
Prosojni solarni paneli zvenijo skorajda kot pravljica. Imajo namreč ves potencial, da mesta iz potrošnikov energije spremenijo v ene večjih proizvajalcev energije. Nižji ogljični...
Serratie, rožnata sluz v kopalnici: Kako se je znebiti?
Rožnato sluz na robu umivalnika, kadi ali stranišča običajno povzroča bakterija Serratia marcescens, zdravju škodljiva bakterija, ki se razmnožuje v vlažnem okolju. Kako se...
Nastavljiva miza: rešitev za domačo pisarno ali otroško sobo
Nastavljiva miza je v zadnjem času vse pogostejša izbira tako za delo od doma kot za šolarje. Poglejmo si nekaj prednost, ki jih prinašajo...
Kako urediti sobo za šolarja
Seveda vsak starš otroško sobo ureja po svojih zmožnostih. Prilagoditi se je treba prostoru in financam, ki jih imamo na razpolago za ureditev. Vseeno...
Kako se rešiti muh?
So tudi vaš dom preplavile nadležne muhe? Kljub temu, da jih preganjate, se vsakič znova vrnejo, vsakič, ko pogledate, pa je v dnevni še...